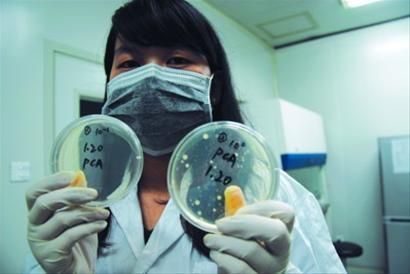
饮水机脏了怎么清洗教你一招,饮水机怎么清洗才有效

饮水机,是家家户户都有的小家电,必不可缺。
饮水机是用来喝水的,用的是桶装纯净水,怎么会脏呢?你是不是有这样的疑问?
饮水机就是用来喝水的,所以我们更要注意饮水机的卫生状况。

首先,我们先了解一下饮水机的工作原理:利用空气压力,经过塑料管,胶管以及内胆,形成一个水循环系统。塑料管和胶管时间长了会风化的,自然会有小塑料渣渣掉下来。
其次,冷水机有两个内胆,一个冷水胆,一个热水胆,热水放出来,又有冷水进去填充。在这两个水胆中就已经有很多杂质沉淀了,喝完水换下桶,水胆里是还有一矿泉水瓶以上的水,这些水已经跟空气接触了很多次,悄悄的滋生了细菌。

一桶水放的时间越长,细菌越多。
在换水的时候,你仔细观察一下,接口处黏黏的,滑滑的,甚至有黄色的不明物质,这就是细菌的温床。
饮水机的内部,是潮湿的环境,经常积水,就会长出微生物,就算是再干净的水,从这些地方流过,都会带上细菌。
尽管现在科学技术进步很快,但是还是有一部分的饮水机是循环加热的,更容易产生水垢,时间长了也会对水造成污染。

最后一个很容易让大家忽视的污染源,就是运输过程中接触的各种细菌。水肯定是经过杀菌消毒了的,桶内部也是消毒了的,外部就不一定了。在运输过程中,聪明盖那块很容易接触外界的细菌,然后换水的时候,聪明盖与饮水机底座接触,在潮湿的地方更容易滋生细菌。
据国家环境卫生监测部门的检测结果显示,饮水机3个月不洗,内胆就会滋生大量细菌,大肠杆菌、沙门氏菌、葡萄球菌等等,数量最高能达到100000个/ml,经常喝这样的水,会生什么病我就不知道了,但是一句话,所有的病都不是突发的,而是累积起来的病,所有不要存在侥幸心理。
总结:饮水机最脏的地方在内胆、进水口、出水口、底座。
平时使用饮水机一定要注意:
1. 一桶水一定要在一周内饮用完毕
2. 保持接水槽干燥,及时倒掉里面的水
3. 多多使用饮水机,保持水是经常流动的
4. 经常擦洗底座、出水口
5. 需要外出的话,先把水桶内的水倒掉,然后打开饮水机后面的排污口排干净内胆的水
我是GiHOME,关注你的健康生活,更关心你。咱们下期见!